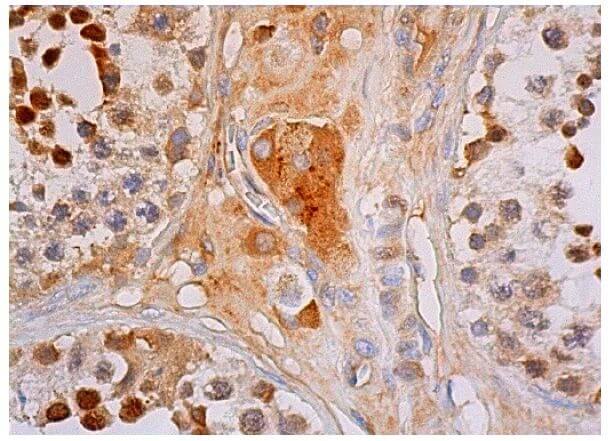

SIRT1 Mouse Monoclonal Antibody (33.36)
CAT.NO. : ARA3336
US$ Please choose
US$ Please choose
Size:
Trail, Bulk size or Custom requests Please contact us
*产品价格可能会有所调整,请以品牌方官网实时更新的价格为准,以确保准确性。
BACKGROUND
The silent information regulator (SIR2) family of genes are highly - conserved from prokaryotes to eukaryotes and are involved in diverse processes, including transcriptional regulation, cell cycle progression, DNA - damage repair and aging. In S. cerevisiae, Sir2p deacetylates histones in a NAD - dependent manner, which regulates silencing at the telomeric, rDNA and silent - mating - type loci. Sir2p is the founding member of a large family, designated sirtuins, which contain a conserved catalytic domain. The human homologs, which include SIRT1 - 7, are divided into four main branches: SIRT1 - 3 are class I, SIRT4 is class II, SIRT5 is class III and SIRT6 - 7 are class IV. SIRT1, which has the closest homology to the yeast Sir2p and is widely expressed in fetal and adult tissues. SIRT1 is highly expressed in heart, brain and skeletal muscle, with low expression in lung and placenta. SIRT1 regulates the p53 - dependent DNA damage response pathway by binding to and deacetylating p53, specifically at Lys 382.
Application
SIRT1 (33.36) is recommended for detection of SIRT1 of mouse, rat and human origin by Western Blotting (starting dilution 1:200, dilution range 1:100 - 1:1000), immunoprecipitation [1 - 2 µg per 100 - 500 µg of total protein (1 ml of cell lysate)], immunofluorescence (starting dilution 1:50, dilution range 1:50 - 1:500), immunohistochemistry (including paraffin - embedded sections) (starting dilution 1:50, dilution range 1:50 - 1:500) and solid phase ELISA (starting dilution 1:30, dilution range 1:30 - 1:3000).
Data

SIRT1 (33.36. Western blot analysis of SIRT1 expression in NTERA - 2 cl.D1 (A), K - 562 (B), BJAB (C) and SUP - T1 (D) whole cell lysates.
SIRT1 (33.36). Immunoperoxidase staining of formalin fixed, paraffin - embedded human testis tissue showing nuclear or cytoplasmic staining of cells in seminiferous ducts and cytoplasmic staining of Leydig cells.
New Products
Datasheet
